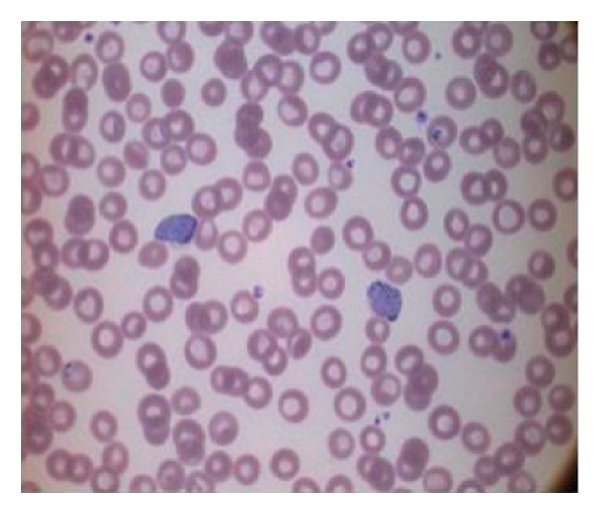

Description
| Method: | Microscopic Examination |
| Comment: | |
| Price: | 200.00 |
| Report: | Daily |
| Usage: | Malaria is a mosquito borne parasitic infection spread by female Anopheles mosquito infected by Plasmodium / malarial parasite. Malaria is transmitted by the bite of an infected mosquito; if you receive infected blood transfusion from a malaria patient; from an infected mother to the baby during pregnancy. It is prevalent in subtropical and tropical parts of the world. This test helps in species identification. It also detects other hemoparasites if present. |
| Doctor Specialty: | Physician |
| Disease: | Infections |
| Components: | |
| Courier Charges: | 0.00 |
| Home Collection: | Available |
| Department: | |
| Pre Test Information: | No special preparation required |